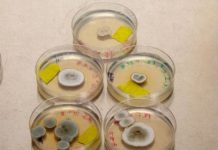
Research: Are no-fun fungi keeping fertilizer from plants? —

Research: Data flows from NASA’s TESS Mission, leads to discovery of Saturn-sized planet —
Astronomers who study stars are providing a valuable assist to the planet-hunting astronomers pursuing the primary objective of NASA's new TESS Mission.
In fact,...
Research: New cryptic bird species discovered —
In the lush, lowland rainforests on the island of Borneo lives a rather common, drab brown bird called the Cream-vented Bulbul, or Pycnonotus...
Research: Freshwater coastal erosion alters global carbon budget —
Shoreline erosion can transform freshwater wetlands from carbon-storage pools to carbon sources, according to a new study led by Illinois State Geological Survey...
Research: New brain research challenges our understanding of sleep —
An international study headed by researchers from Aarhus University has for the first time uncovered the large-scale brain patterns and networks in the...
Research: Microglia may benefit, not damage, photoreceptors —
National Institutes of Health scientists studying the progression of inherited and infectious eye diseases that can cause blindness have found that microglia, a...
Research: Resting postures determined by animals’ size —
Why do we never see cows lying on their sides in fields? In ruminants such as cows, sheep, antelopes, deer and giraffes, the...
Research: Are no-fun fungi keeping fertilizer from plants? —
Crops just can't do without phosphorus. Globally, more than 45 million tons of phosphorus fertilizer are expected to be used in 2019. But...
Research: Future of elephants living in captivity hangs in the balance —
Scientists at the University of Sheffield and University of Turku are looking at ways to boost captive populations of Asian elephants without relying...
Research: A complex relationship —
Artificial light is rightly considered a major social, cultural and economic achievement. Yet, artificial light at night is also said to pose a...
Research: ‘Nightmarish’ antlions’ spiral digging techniques create effective and deadly traps —
A team of biologists and physicists, led by the University of Bristol, have uncovered new insights into how antlions -- one of the...
Top News
Hey ISIS, You Suck: Local Muslims Post Anti-ISIS Billboard
A new billboard on Manchester Road in Missouri reads, "HEY ISIS, YOU SUCK!!! From: #ActualMuslims."
A group of Muslim-Americans have put up a blunt billboard...